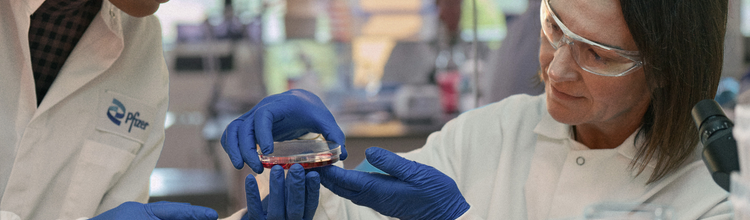

We strengthened our foundation and made significant progress toward driving future breakthroughs for patients around the world.
Dr. Albert Bourla
Chairman & Chief Executive Officer
Dear Shareholders,
Pfizer made great strides in 2025.
It was a year of strong performance, disciplined execution and bold moves to position us for future growth and lasting impact for patients around the world.
We delivered on our financial commitments, sharpened our strategy and strengthened the foundation for what’s next. Our focus was clear: Guided by our purpose, we advanced science, accelerated innovation and helped patients gain access to the medicines and vaccines they needed.
Our R&D pipeline is sharply focused on opportunities where we believe Pfizer’s scientific leadership and robust capabilities can make the greatest difference. Last year, we made progress with high-priority internal programs and completed strategic deals, including the acquisition of Metsera, Inc., and our in-licensing agreements with 3SBio, Inc., and YaoPharma Co., Ltd.
Our U.S. and International Commercial teams were outstanding in turning scientific progress into real-world outcomes. We strengthened our leadership for key products while also building trust with clinicians making treatment decisions and patients navigating care.
We’re striving to increase the speed of everything we do to drive high-quality innovation to improve lives. 2025 was a year of progress, with improved productivity and margins made possible, in part, by simplifying and streamlining our business.
We also reached a landmark voluntary agreement with the U.S. Government, supporting efforts to lower prescription drug costs and align prices with those in other developed countries.1 This removed uncertainties by providing greater clarity on pricing and a three-year grace period from certain U.S. tariffs.
With our performance, investments in our future and key strategic milestones, 2025 was a pivotal year. We are confident that we’re positioning Pfizer for growth toward the end of the decade, continued impact for patients and long-term shareholder value.

Making a Difference for Patients

Performance
Top 10 Medicines and Vaccines
Take a look at our breakdown of the top medicines and vaccines by revenue from 2025.
Select an option below
$7,961 million
ELIQUIS® (apixaban)4
ELIQUIS®4
(apixaban)
13%
of total revenue in 2025
$6,494 million
PREVNAR® Family5
PREVNAR® Family5
10%
of total revenue in 2025
$6,380 million
VYNDAQEL® Family6
VYNDAQEL® Family6
10%
of total revenue in 2025
$4,367 million
COMIRNATY®7
COMIRNATY®7
7%
of total revenue in 2025
$4,122 million
IBRANCE® (palbociclib)
IBRANCE®
(palbociclib)
7%
of total revenue in 2025
$2,362 million
PAXLOVID® (nirmatrelvir tablets and ritonavir tablets)
PAXLOVID®
(nirmatrelvir tablets and ritonavir tablets)
4%
of total revenue in 2025
$2,194 million
XTANDI® (enzalutamide)8
XTANDI®8
(enzalutamide)
4%
of total revenue in 2025
$1,940 million
PADCEV® (enfortumab vedotin-ejfv)
PADCEV®
(enfortumab vedotin-ejfv)
3%
of total revenue in 2025
$1,424 million
NURTEC ODT®/VYDURA® (rimegepant)
NURTEC ODT®/VYDURA®
(rimegepant)
2%
of total revenue in 2025
$1,087 million
XELJANZ® (tofacitinib)
XELJANZ®
(tofacitinib)
2%
of total revenue in 2025
With strong financial discipline, cost reduction programs helped us expand our operating margin and improve operational efficiency. We made significant progress through year-end 2025 and our cost realignment program is expected to deliver total net cost savings of approximately $5.7 billion by the end of 2026. Additionally, we realized approximately $600 million in net cost savings by year-end 2025 with the first phase of our manufacturing optimization program, which is on track to deliver approximately $1.5 billion in net cost savings by the end of 2027.
In 2025, we returned $9.8 billion to shareholders via our quarterly dividend. We also invested $10.4 billion in internal R&D and approximately $8.8 billion in business development transactions, primarily reflecting the Metsera acquisition and the 3SBio in-licensing deal. Our capital allocation strategy is designed to enhance long-term shareholder value, with priorities that include maintaining and, over the long term, growing our dividend, reinvesting in the business and, in the future, the potential to make share repurchases after de-leveraging our balance sheet. We expect to continue to de-lever over the longer term to maintain a balanced capital allocation strategy.
Financial Performance
Three-year summary for the years ended December 31
* Indicates calculation not meaningful or results are greater than 100%.
Detailed information on our financial and operational performance can be found in our 2025 Annual Report on Form 10-K.
Our Innovation Engine
Pfizer is dedicated to breakthrough medicines and vaccines that help people live better, longer lives.
In 2025, we refocused our innovation engine by unifying our R&D organization and sharpening our strategy. We’re aiming for differentiated leadership in the therapeutic areas of Oncology, Internal Medicine, Vaccines and Inflammation & Immunology.
It was a very successful year of execution. We’re pleased with high-quality results in key programs that have the potential to create significant value for both patients and shareholders.
Oncology was a continued source of strength. Our progress included a series of potentially practice-changing data read-outs, regulatory approvals and multiple Phase 3 study starts.
We also reinvigorated Pfizer’s presence in obesity with the acquisition of Metsera. This is another example of a bold strategic move leveraging Pfizer’s strengths. We intend to use the scale of our global clinical, manufacturing and commercial capabilities to accelerate development of the acquired investigational portfolio.
Innovating to Address Unmet Needs in Obesity Care
More than 1 billion people worldwide are living with obesity, a complex medical condition linked to over 200 related health problems – from heart disease to diabetes and many other serious conditions.11 Despite recent treatment breakthroughs, we believe millions of patients could benefit from better options. At Pfizer, we’re committed to helping them as we seek to improve outcomes in what is expected to become a $150 billion market.12

Our acquisition of Metsera builds on Pfizer’s strong track record in cardiometabolic medicine. Just as we did with LIPITOR®, NORVASC® and ELIQUIS® – therapies that changed intervention for high cholesterol, blood pressure and stroke prevention – we’re aiming to lead again with potential next-generation obesity treatments.13
The Metsera portfolio includes innovative investigational approaches to treating obesity. Subject to clinical trial success and regulatory approval, we’re encouraged by the potential for robust weight loss results complemented by the convenience of once-monthly dosing. We’re also confident in the potential for a tolerability profile that’s competitive within this class of medicines. Along with the YaoPharma GLP-1 receptor agonist candidate currently in Phase 1 clinical development for chronic weight management and other Pfizer programs, we have a robust and diverse clinical-stage obesity pipeline that gives us multiple paths toward potential success.
We have manufacturing strength, a proven field force and direct-to-patient interactions to deliver at scale. We are confident that we’re on our way to creating meaningful value for patients and shareholders as we strive for Pfizer leadership in this area of significant need.
Attacking Cancer From Multiple Angles
Cancer remains one of healthcare’s most formidable challenges. More than 2.5 million patients globally are diagnosed each year with lung cancer alone.14 The five-year survival rate is just 32% for non-small cell lung cancer and only 9% for small cell lung cancer.15 Colorectal cancer is the second-leading cause of cancer death in the United States.16 Despite meaningful progress in oncology treatment, patients urgently need better options.
Pfizer is well positioned to deliver potential breakthroughs through our Oncology pipeline, including PF’4404, a promising cancer immunotherapy candidate we obtained in the 3SBio in-licensing agreement. This next-generation investigational medicine is a PD-1 x VEGF bispecific antibody with the potential to become a backbone therapy across multiple tumor types, including thoracic, genitourinary and gastrointestinal cancers.
We have deep expertise in multi-specific antibody development, an established presence in key disease areas, a global clinical network spanning more than 500 sites and over 50 medical oncologists empowered to move with speed and precision.
We’re also seeking an advantage by combining different treatment approaches. Early research shows that our vedotin-based antibody-drug conjugates, or ADCs, might work especially well with medicines that help the immune system fight cancer. By pairing ADCs with our investigational ’4404 medicine, which targets two key cancer pathways, we’re exploring a way to attack cancer from multiple angles while aiming to reduce side effects.
We’re making significant progress with a development strategy built on speed, breadth and depth. This isn’t just about sophisticated science; it’s about making a real difference for patients by seeking to change how cancer is treated and creating value in a global market projected to reach $70 billion by 2030.17
Our Manufacturing Advantage
Pfizer has one of the most advanced and expansive manufacturing and supply networks in the world - driven by speed, scale and science
Among our global network, Pfizer has more manufacturing facilities in the United States than in any other single country. We have one of the largest U.S. internal pharmaceutical manufacturing networks, with a total of 13 manufacturing and distribution facilities. Nearly 40% of our colleagues work in our global network, guiding the production of about 45 billion doses of more than 500 medicines and vaccines each year for approximately 200 countries and territories. Our reach and expertise give us a differentiated ability to deliver when it matters most, whether for routine care or urgent global health challenges.
Few companies can match what our team does. By the end of 2025, Pfizer reached an extraordinary milestone in our mission to help protect global health: the delivery of the 3-billionth dose of Prevnar, when counting current and past versions of our pneumococcal conjugate vaccine. This was a powerful example reinforcing Pfizer’s leading ability to produce vaccines at scale. With one of the largest global manufacturing networks in the biopharmaceutical industry, we’re able to deliver high-quality vaccines rapidly and reliably to communities worldwide.

As we look ahead, I’m excited about our opportunity to build on this legacy of success and impact. We’re expanding our use of cutting-edge technologies as we strive to make our manufacturing even faster, smarter and more sustainable.
Expanding Access
At Pfizer, we aspire for health and well-being for all through equitable access to medicines and vaccines across the United States and around the world.
We’re proud of our longstanding partnerships with governments, non-governmental organizations (NGOs) and private-sector leaders to advance global health. In 2022, we launched Accord for a Healthier World, a groundbreaking initiative aiming to provide our entire portfolio of medicines and vaccines, for which we have global rights, to 45 lower-income countries on a not-for-profit basis. In 2025, we reached nearly 800,000 patients through the Accord – a fourfold increase from the previous year. The program enabled delivery of about 70 Pfizer medicines and vaccines across multiple therapeutic areas to at least one country, including many first-time introductions, while supporting health systems through over 16,000 engagements with healthcare and supply chain professionals. This shows the progress we’re making and reflects our belief that access should never be a privilege.
Our partnership goes further. Through our collaborations with Gavi, the Vaccine Alliance, and global health-focused organizations across multiple therapeutic areas, including women’s health, sexual and reproductive health, oncology and infectious disease, our collective efforts have reached more than 45 million people across 100 countries. This demonstrates the scope and magnitude of Pfizer’s commitment to health equity.
We believe that where a woman lives should never determine whether she survives cancer, and we are supporting innovative solutions to help. Through The Pfizer Foundation, we’re addressing disparities in cancer care through programs like Action & Impact, a three-year, $25 million investment supporting global health NGOs committed to improving the health of women and families worldwide.18,19 Our partners are working with ministries of health in sub-Saharan Africa to address key barriers to timely breast cancer diagnosis and treatment.
We believe that where a woman lives should never determine whether she survives cancer
Community health centers are often the first point of care for more than 30 million people across the United States. Through The Pfizer Foundation’s Innovation Awards in Community Health program, in partnership with Direct Relief, we’re funding safety-net clinics to support vaccine education and access for vulnerable populations.

Scaling AI Impact
We’ve made bold, strategic investments in digital transformation as we continually reimagine how medicines and vaccines are discovered, developed and delivered. Over the past several years, our teams have moved to shape future innovation with powerful artificial intelligence (AI) tools.
As we enter 2026, AI has become a key element in how we work, driving innovation and productivity across every facet of our business.
AI is accelerating innovation and improving productivity across every facet of our business
In R&D, our scientists face the difficult task of identifying the targets and molecules most likely to succeed. AI is helping to power this work across discovery, development, regulatory and medical.
Pfizer’s field force has often set the standard in our industry. To help our Commercial colleagues work smarter, we built an AI-powered planning platform that helps us connect with healthcare providers at the right moment with the right information. Ultimately, this can mean greater access for patients and stronger support for clinicians.
In an AI-enabled future, data, adaptability and the drive to innovate will provide an important competitive edge. To meet the growing AI demand, over the next two years, we’re expanding to more than 1,200 GPUs, the fundamental infrastructure powering modern AI. I’m confident that with our expertise, ambition and commitment to moving fast, Pfizer will be ready to lead the way.
Executing Today, Building for Tomorrow
Our strategy is clear: Invest and execute today as we build for future growth.
In 2025, we delivered strong results, advanced innovation and strengthened our foundation. With a sharpened R&D pipeline, leading commercial capabilities and a world-class manufacturing network, we’ve entered 2026 with a bold strategy and confidence that we’re making progress toward creating lasting value for patients and our shareholders.
Thank you for your trust and support as we continue to pursue breakthroughs that change patients’ lives.

Dr. Albert Bourla
Chairman & Chief Executive Officer
- Pfizer. Pfizer Reaches Landmark Agreement with U.S. Government to Lower Drug Costs for American Patients. Published September 30, 2025. Accessed November 4, 2025. https://www.pfizer.com/news/press-release/press-release-detail/pfizer-reaches-landmark-agreement-us-government-lower-drug
- The Patients Reached metric is calculated from Pfizer and third-party datasets. Figures may be limited given the coverage provided by external sources (e.g., calendar duration, geographic and product coverage) and are subject to change. Numbers are estimates and, in some cases, use global volume, daily dosage and number of treatment days to facilitate calculations. Methodologies to calculate estimates may vary by product type given the nature of the product and available data. Patients taking multiple Pfizer products may be counted as multiple patients toward the total. Numbers include estimated patient counts from our “An Accord for a Healthier World” program. Numbers do not include comprehensive estimated patient counts from ex-U.S. patient support programs. Historical estimates may periodically be subject to revision due to restatements in the underlying data source.
- References to operational variances in this Annual Review pertain to period-over-period changes that exclude the impact of foreign exchange rates. Although foreign exchange rate changes are part of Pfizer’s business, they are not within Pfizer’s control and, because they can mask positive or negative trends in the business, Pfizer believes presenting operational variances excluding these foreign exchange changes provides useful information to evaluate Pfizer’s results. For additional information on the company’s operational revenue performance, see the Our 2025 Performance – Total Revenues and the Analysis of the Consolidated Statements of Operations sections in Management’s Discussion and Analysis of Financial Condition and Results of Operation in our 2025 Annual Report on Form 10-K.
- ELIQUIS reflects alliance revenues and product revenues.
- PREVNAR Family includes Prevnar 20/Prevenar 20 (pediatric and adult) and Prevnar 13/Prevenar 13 (pediatric and adult).
- VYNDAQEL Family includes global revenues from VYNDAQEL, as well as revenues for VYNDAMAX in the U.S. and VYNMAC in Japan.
- COMIRNATY refers to, as applicable, the current formulation of COMIRNATY (COVID-19 Vaccine, mRNA) 2025-2026 Formula as well as all prior authorized or approved formulations of the vaccine, which was first authorized in the U.S. during December 2020 pursuant to an Emergency Use Authorization (EUA).
- XTANDI primarily reflects alliance revenues and royalty revenues.
- Reported net income is defined as Net income attributable to Pfizer Inc. common shareholders in accordance with U.S. Generally Accepted Accounting Principles (GAAP). Reported diluted earnings per share (EPS) is defined as diluted EPS attributable to Pfizer Inc. common shareholders in accordance with U.S. GAAP.
- Adjusted income and Adjusted diluted EPS are defined as U.S. GAAP Net income attributable to Pfizer Inc. common shareholders and EPS attributable to Pfizer Inc. common shareholders—diluted before the impact of amortization of intangible assets, certain acquisition-related items, discontinued operations and certain significant items. The Adjusted income and Adjusted diluted EPS measures are not, and should not be viewed as, substitutes for U.S. GAAP net income and diluted EPS, have no standardized meaning prescribed by U.S. GAAP and may not be comparable to the calculation of similar measures of other companies. See the Non-GAAP Financial Measure: Adjusted Income section of Management’s Discussion and Analysis of Financial Condition and Results of Operation in Pfizer’s 2025 Annual Report on Form 10-K for an explanation of how management uses these non-GAAP measures, reconciliations to the most directly comparable U.S. GAAP measures and additional information.
- American Medical Association (accessed September 18, 2025); 2. World Obesity Federation (accessed September 18, 2025); CV: Cardiovascular; MASLD: Metabolic dysfunction-associated steatotic liver disease; MASH: Metabolic dysfunction-associated steatohepatitis.
- BMO Capital Markets, May 2024.
- In November 2020, we spun-off our Upjohn Business, which included Lipitor and Norvasc, and combined it with Mylan to form Viatris.
- World Cancer Research Fund. Lung cancer statistics. Published October 3, 2024. Accessed November 4, 2025. https://www.wcrf.org/preventing-cancer/cancer-statistics/lung-cancer-statistics/
- American Cancer Society. Lung Cancer Survival Rates: 5-Year Survival Rates for Lung Cancer. Published January 29, 2024. Accessed November 4, 2025. https://www.cancer.org/cancer/types/lung-cancer/detection-diagnosis-staging/survival-rates.html
- Siegel RL, Kratzer TB, Giaquinto AN, Sung H, Jemal A. Cancer statistics, 2025. CA: A Cancer Journal for Clinicians. 2025;75(1). doi:https://doi.org/10.3322/caac.21871
- Pfizer Pflash: A Spotlight on the PF’4404 (SSGJ-707 / PF-08634404) Clinical Development Strategy. Published November 10, 2025. Accessed February 6, 2026. https://s206.q4cdn.com/795948973/files/doc_events/2025/Nov/10/PfizerPflash_-4404-SITC-IR-Event-2025_FINAL.pdf
- The Pfizer Foundation is a separate legal entity from Pfizer Inc., with distinct legal restrictions.
- Pfizer. The Pfizer Foundation Expands Breast Cancer Initiative to Kenya and Ethiopia with $10 Million in Grants. Published January 8, 2026. Accessed February 6, 2026. https://www.pfizer.com/news/announcements/pfizer-foundation-expands-breast-cancer-initiative-kenya-and-ethiopia-10-million
About This Review
This review covers Pfizer’s worldwide business and provides information on our activities for the year ended December 31, 2025. It describes key dimensions of our purpose, strategy and performance.
Forward Looking Information
This Annual Review contains forward-looking statements about, among other topics, our anticipated operating and financial performance, including financial guidance and projections; reorganizations; business plans, strategy, goals and prospects; expectations for our product pipeline (including products from completed or anticipated acquisitions), in-line products and product candidates, including anticipated regulatory submissions, data read-outs, study starts, approvals, launches, discontinuations, clinical trial results and other developing data, revenue contribution and projections, pricing and reimbursement, market dynamics, including demand, market size, utilization rates, growth, performance, timing and duration of exclusivity and potential benefits; our efforts to address unmet needs in obesity care; our efforts to deliver potential breakthroughs through our Oncology pipeline; the impact and potential impact of tariffs and pricing dynamics; strategic reviews; leverage and capital allocation objectives; an enterprise-wide cost realignment program (including anticipated costs, savings and potential benefits); a Manufacturing Optimization Program to reduce our cost of goods sold (including anticipated costs, savings and potential benefits); dividends and share repurchases; plans for and prospects of our acquisitions, dispositions and other business development activities, including our acquisitions of Metsera and Seagen and our in-licensing agreements with 3SBio and YaoPharma, and our ability to successfully capitalize on growth opportunities and prospects; our efforts to expand access to our medicines and vaccines; the expected benefits of digital technology and AI; our voluntary agreement with the U.S. Government designed to lower drug costs for U.S. patients and to include certain Pfizer products on the TrumpRx.gov platform, Pfizer’s plans to further invest in U.S. manufacturing and potential tariff impacts; manufacturing and product supply; our expectations regarding the impact of COVID-19 on our business, operations and financial results; the expected seasonality of demand for certain of our products; and our work to operate and advance strategic goals for operating in a responsible and sustainable manner, that are subject to substantial risks and uncertainties. We cannot guarantee that any forward-looking statement will be realized. Should known or unknown risks or uncertainties materialize or should underlying assumptions prove inaccurate, actual results could vary materially from past results, future plans and projected future results.
A further list and description of risks, uncertainties and other matters can be found in Pfizer's Annual Report on Form 10-K for the year ended December 31, 2025, and in Pfizer’s subsequent reports on Form 10-Q, in each case including in the sections thereof captioned “Risk Factors” and “Forward-Looking Information and Factors That May Affect Future Results,” as well as in Pfizer’s subsequent reports on Form 8-K. These reports are available on our website at www.pfizer.com and on the U.S. Securities and Exchange Commission’s (SEC) website at www.sec.gov. The forward-looking statements in this Annual Review speak only as of the original date of this Annual Review, and we undertake no obligation to update or revise any of these statements as the result of new information or future events or developments or otherwise.
Data in review covers the calendar year from January 1 to December 31, 2025, unless otherwise stated.
All trademarks are the property of their respective owners.
COMIRNATY® is a registered trademark of BioNTech SE.
ELIQUIS® is a registered trademark of Bristol-Myers Squibb Company.
LIPITOR® is a registered trademark of Upjohn Manufacturing Ireland Unlimited Company.
NORVASC® is a registered trademark of Viatris Specialty LLC.
XTANDI® is a registered trademark of Astellas Pharma Inc.
Corporate Shareholder Information
Stock Transfer Agent and Registrar
The principal market for our Common Stock is the New York Stock Exchange. Our stock is also traded on various U.S. regional stock exchanges.
Stock Transfer Agent and Registrar
Computershare Investor Services
P.O. Box 43006
Providence, RI 02940-3006
Telephone: (800) 733-9393
Outside the United States, Canada and Puerto Rico:
(781) 575-4591
Internet: www.computershare.com/investor
Shareholder Services and Programs
Please contact our Stock Transfer Agent and Registrar, Computershare, with inquiries concerning shareholder accounts of record and stock transfer matters, and for information on the following services and programs:
- Computershare Investment Program
- Direct purchase of Pfizer stock
- Dividend reinvestment
- Automatic monthly or bi-monthly investments
- Book-entry share ownership
- Direct deposit of dividends
Pfizer Public Policy Engagement for Global Public Health
Learn more about public policy at Pfizer:
www.pfizer.com/purpose/contributions-partnerships/political-partnerships
Useful Links
https://investors.pfizer.com/Investors/Overview/
https://www.pfizer.com/contact
https://www.pfizer.com/Privacy
https://www.pfizer.com/about/careers
https://www.pfizer.com/general/terms
Additional Information
Find more information about Pfizer online:
www.pfizer.com
www.facebook.com/Pfizer
www.instagram.com/pfizerinc/
www.youtube.com/Pfizer
www.linkedin.com/company/pfizer
www.x.com/Pfizer
We may use our website as a means of disclosing material information and for complying with our disclosure obligations under Regulation Fair Disclosure promulgated by the SEC. These disclosures are included on our website in the “About—Investors” or “Newsroom” sections. Accordingly, investors should monitor these portions of our website, in addition to following our press releases, SEC filings, public conference calls and webcasts, as well as our social media channels (our Facebook page, Instagram account, YouTube page and LinkedIn page and X (formerly known as Twitter) accounts).
The information contained on our website, our Facebook, Instagram, YouTube and LinkedIn pages or our X accounts, or any third-party website, is not incorporated by reference into this 2025 Annual Review.
The 2025 Annual Review may contain references or links to other websites maintained by third parties over whom Pfizer has no control. Such links are provided merely as a convenience. Pfizer makes no warranties or representations of any kind as to the accuracy, currency or completeness of any information contained in such third-party websites. Inclusion of any third-party link in this 2025 Annual Review does not imply an endorsement or recommendation by Pfizer and a link to this 2025 Annual Review from another website does not imply a relationship between Pfizer and any third party. Your use of any such third-party site or platform is at your own risk and will be governed by such third party’s terms and policies (including its privacy policy).